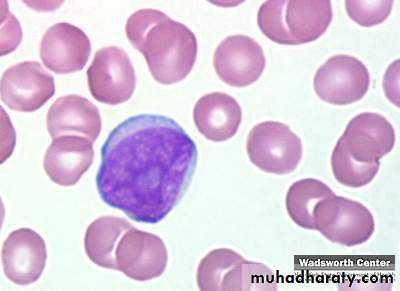
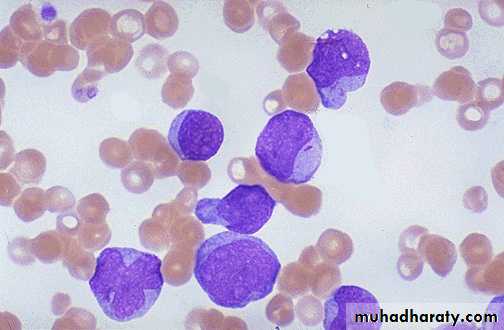

Fifth stage
medicineLec-
د.خالد
9/11/2015
ACUTE LEUKEMIAOBJECTIVE Define acute leukemia Classify leukemia Understand the pathogenesis Understand the pathophysiology Able to list down the laboratory investigations required for diagnosis Understand the basic management of leukemia patientsLeukemia Incidence of leukaemia of all types; 10/100 000 per annum, of which just under half are cases of acute leukaemia.
Classification : Acute M : F 3:2 Acute lymphoblastic leukemia (T-ALL & B-ALL) Acute myeloid leukemia Chronic Chronic myeloid leukemia M:F 1.3: 1 Chronic lymphocytic leukemia M : F 2:1Acute Leukaemia Define : heterogenous group of malignant disorders which is characterised by uncontrolled clonal and accumulation of blasts cells in the bone marrow and body tissues Sudden onset If left untreated is fatal within a few weeks or months
FAB Acute Myeloid LeukemiaAcute nonlymphocytic (ANLL) % Adult cases
M0 Minimally differentiated AML 5% - 10%Negative or < 3% blasts stain for MPO ,PAS and NSEblasts are negative for B and T lymphoid antigens, platelet glycoproteinsand erythroid glycophorin A.Myeloid antigens : CD13, CD33 and CD11b arepositive.
M1 Myeloblastic without maturation 10 - 20% >90% cells are myeloblasts3% of blasts stain for MPO+8 frequently seenFAB –AML cont.
M2 AML with maturation 30 - 40%30% - 90% are myeloblasts~ 15% with t(8:21)FAB FOR AML con.
3 Acute Promyelocytic Leukemia (APML) 10-15%marrow cells hypergranular promeyelocytesAuer rods/ faggot cells may be seenClassical-Hypergranular, 80% leukopaenic Variant-Hypogranular, leukocytosisGranules contain procoagulants (thromboplastin-like) - massive DICt(15:17) is diagnosticFAB-AML-cont.
M4 Acute Myelomonocytic Leukemia 10-15%Incresed incidence of CNS involvementMonocytes and promonocytes 20% - 80%M4 with eosinophilia ((M4-Eo), assoc with del/inv16q– marrow eosinophil from 6% - 35%,FAB-AML-cont.
M5a Acute Monoblastic Leukemia 10-15%M5b AMoL with differentiation <5% Often asso with infiltration into gums/skinWeakness, bleeding and diffuse erythematous skin rashFAB-AML-cont.
M6 Erythroleukemia (Di Guglielmo) <5%50% or more of all nucleated marrow cells are erythroid precursors,and 30% or more of the remaining nonerythroid cells are myeloblasts (if <30% then myelodysplasia)FAB-AML-cont.
M7 Acute Megakaryoblastic Leukemia <5%Assoc with fibrosis(confirm origin with platelet peroxidase + electron microscopy or MAb to vWF orglycoproteins
FAB- Acute Lymphoblastic LeukemiaAcute lymphoblastic leukemia
(ALL)*
L-1 85%
L-2 14%
L-3 (Burkitt's)1% childhood
Acute LeukaemogenesisDevelop as a result of a genetic alteration within single cell in thebone marrowa) Epidemiological evidence :1. Hereditary Factors Fanconi’s anaemia Down’s syndrome Ataxia telangiectasiaAcute Leukaemogenesis2. Radiation,Chemicals andDrugs3. Virus relatedLeukemias Retrovirus :-HTLV 1 & EBVAcute Leukaemogenesisb)Molecular Evidence Oncogenes : Gene that code for proteins involved incell proliferation or differentiation Tumour Suppressor Genes : Changes within oncogene or suppressor genes are necessary to cause malignant transformation.Oncogene can be activated by : chromosomal translocation point mutations inactivation In general, several genes have to be alteredto effect neoplastic transformation.
Pathophysiology Acute leukemia cause morbidity andmortality through :- Deficiency in blood cell number andfunction Invasion of vital organs Systemic disturbances by metabolicimbalance
A. Deficiency in blood cell number or functioni. Infection- Most common cause of death- Due to impairment of phagocytic function and neutropeniaii. Hemorrhage- Due to thrombocytopenia or 2o DIVC or liver diseaseiii. Anaemia- normochromic-normocytic- severity of anaemia reflects severity of disease- Due to ineffective erythropoiesis B. Invasion of vital organs- vary according to subtypei.Hyperleukocytosis- cause increase in blood viscosity- Predispose to microthrombi or acute bleeding- Organ involve : brain, lung, eyes- Injudicious used of packed cell transfusion precipitatehyperviscosityii. Leucostatic tumour- Rare- blast cell lodge in vascular system forming macroscopicpseudotumour – erode vessel wall cause bleedingiii. Hidden site relapse- testes and meningesPathophysiologyC. Metabolic imbalance- Due to disease or treatment- Hyponatremia vasopressin-like subst. bymyeloblast- Hypokalemia due to lysozyme release bymyeloblast- Hyperuricaemia- spont lysis of leukemicblast release purines into plasma
Acute Lymphoblastic Leukaemia
Cancer of the blood affecting the white bloodcell known as LYMPHOCYTES. Commonest in the age 2-10 years Peak at 3-4 years. Incidence decreases with age, and asecondary rise after 40 years. In children - most common malignantdisease 85% of childhood leukaemiaSpecific manifestation :*bone pain, arthritis*lymphadenopathy*hepatosplenomegaly*mediastinal mass*testicular swelling*meningeal syndrome
Acute Myeloid Leukemia Arise from the malignant transformationof a myeloid precursor Rare in childhood (10%-15%)
The incidence increases with age 80% in adults Most frequent leukemia in neonateSpecific manifestation :- Gum hypertrophy Hepatosplenomegaly Skins deposit Lymphadenopathy Renal damage DIVC
Investigations1. Full blood count reducedhaemoglobinnormochromic, normocytic anaemia, WBC<1.0x109/l to>200x109/l,neutropenia andblast cells Thrombocytopenia <10x109/l).
Acute lymphoblasticleukemia
Acute myeloid leukemia
ALL(Lymphoblast) AML (Myeloblast) Blast size :small Large Cytoplasm: Scant Moderate Chromatin: Dense Fine, Lacy Nucleoli :Indistinct Prominent Auer-rods: Never Present in 50% present 2.Bone marrowaspiration andtrephine biopsy confirm acute leukaemia (blast > 20%)
usually hypercellular
3.Cytochemical staininga) Peroxidase :- * negative ALL * positive AML
Positive for myeloblast
b)Periodic acid schiff*Positive ALL(block)* Negative AML
Block positive in ALL
c)Acid phosphatase :focal positive(T-ALL)
4.Immunophenotyping identify antigens present on the blast cells determine whether the leukaemia is lymphoidor myeloid(especially important when cytochemicalmarkers are negative or equivocal. E.g : AML-MO) differentiate T-ALL and B-ALL
-Certain antigens have prognostic significance-Rare cases of biphenotypic where both myeloid and lymphoid antigenare expressed on the same blast cells.-Able to identify the subtype ofleukemia. E.g : AML-M7 has aspecific surface marker of CD 61etc.
Monoclonal antibodies(McAb)
Are group based on antigen on the leucocytes and are recognisedunder a cluster of differentiation(CD).monoclonal antibodies used for characterisation of alland aml.
AML : CD13, CD33ALL : B-ALL CD10, CD 19, CD22T-ALL CD3, CD7
5.Cytogenetics and molecular studies detect abnormalities within the leukaemic clone diagnostic or prognostic value E.g : the Philadelphia chromosome :the product of a translocation between chromosomes 9 and 22 confers a very poor prognosis in ALLInvestigationsCOMMON CHROMOSOME ABNORMALITIESASSOCIATED WITH ACUTE LEUKEMIA t(8;21) AML with maturation (M2) t(15;17) AML-M3(APML) Inv 16 AML-M4 t(9;22) Chronic granulocytic leukemia t(8;14) B-ALL
Others Invx6. Biochemical screening leucocyte count very high - renalimpairment and hyperuricaemia7. Chest radiography mediastinal mass - present in upto 70% of patients with T -ALLIn childhood ALL bone lesions mayalso seen.Others Invx8.Lumbar puncture initial staging inv. to detect leukaemiccells in the cerebrospinal fluid,indicating involvement of the CNS
ManagementSupportive care1.Central venous catheter inserted to :facilitate blood productadm. of chemotherapy and antibioticsfrequent blood samplingManagement2.Blood support :--platelet con. for bleeding episodes or ifthe platelet count is <10x109/l withfever-fresh frozen plasma if the coagulationscreen results are abnormal- packed red cell for severe anaemia(caution : if white cell count isextremely high)Blood products :-Transfusion of whole blood, even when fresh isonly useful to replace blood loss .-3 important points should be rememberedwhen indicating blood transfusion1-For pt presenting with high WBC count, overshould not be given blood before WBC count isreduced.2-For pts on IV drips, diuretics will be requiredto cover blood transfusion.3-Large volumes of blood will result in plateletdilutionManagement3.Prevention and control infection-barrier nursed-Intravenous antimicrobial agents ifthere is a fever or sign of infection
Prophylaxis of infection1-protective isolation in the form of single room.2-Insertion of a central venous line (Hickmanline)3-Gut decontamination a typical regimencombines colistin + ciprofloxacin andfluconazole with oral amphotericin andbetadine mouth-washes. Children neomycininstead of ciprofloxacinProphylaxis for infection (Cont.)4-Measures to reduce the number ofpathogenic organism in the skin by usingsolution or creams of chlorhexidene andantiseptic soaps. Oral hygiene, clean food,avoid fresh salads, fresh fruits.Antifungal lozenges, &Tb prophylaxsis INH5-Growth factor. G-CSF, GM-CSF from 6 daysafter the end of chemotherapy until WBCcount > 1.0x109/L ..INFECTIONS In febrile neutropenic patients the mostcommon pathogenic organisms : Gram negative(Klebsiella and enterobacter spp.Pseudomonas, E. coli, proteus) originate frompatient own gut bacterial flora. - Gram positive organism , staph. epidermidis, staph.aureus & streptococcus (Flora of skin and mucousmembrane). -Fungal infections : candida albicans,Aspergellus.
Treatment of Established infectionAny consistent ( > 4 hrs) elevation intemp. to 38.0oC or more requiresimmediate blood culture and institutionof broad spectrum antibiotic.Treatment of Established infection(cont) Third generation cephalosporin(ceftazidime) Penicillin with extended spectrum(piperacillin or azlocillin) Carbapenems (meropenem,imipenem) Monobactam (Aztroneam)
- In Acute Llymphoblastic Leukaemia pts aresusceptible to pneumocystis carenii(jirovecii)causing severe pneumomia. Treatment: highdose co-trimoxazole initially IV then change tooral treatment.4.Physiological and social support
Drugs commonly used in the treatment ofacute leukaemia
Specific treatmentUsed of cytotoxic chemotherapy. Aim : To induce remission (absence of any clinical or conventionallaboratory evidence of the disease) To eliminate the hidden leukemic cells
Cytotoxic chemotherapy Anti-metabolites Methotrexate Cytosine arabinoside Act: inhibit purine & pyrimidine synt or incorp into DNA S/E : mouth ulcer, cerebellar toxicity
DNA binding Dounorubicin Act : bind DNA and interfere with mitosis S/E : Cardiac toxicity, hair lossCytotoxic chemotherapy
Mitotic inhibitors Vincristine Vinblastine Act : Spindle damage, interfere with mitosis S/E : Neuropathy, Hair loss
Others Corticosteroid Act : inhibition or enhance gene expression Trans-retinoic acid Act : induces differentiationATRA (all trans retinoic acid) in acute promyelocytic leukaemia, which hasgreatly reduced induction deaths from bleeding in this good-risk leukaemia.Complications of cytotoxic drug
Early side effects nausea and vomiting mucositis, hair loss, neuropathy, andrenal and hepatic dysfunction myelosuppression
ComplicationsLate effects Cardiac–Arrhythmias, cardiomyopathy Pulmonary–Fibrosis Endocrine–Growth delay,hypothyroidism, gonadal dysfunction Renal–Reduced GFR Psychological–Intellectualdysfunction, Second malignancy Cataracts
Outcome in adult acute leukaemia